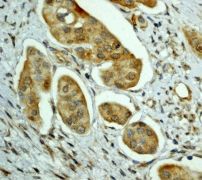

> Antigen, Antibodies, ELISA, Western Blot > Primary Antibody > Monoclonal Antibodies > MARK3 AntibodyBrand |
Leading Biology | Catalog Number |
APR17319G |
Product Type |
Monoclonal Antibodies | Field of Research |
|
Product Overview |
We constantly strive to ensure we provide our customers with the best antibodies. As a result of this work we offer this antibody in purified format.
We are in the process of updating our datasheets. If you have any questions regarding this update, please feel free to contact our technical support team.
This product is a high quality MARK3 antibody.
|
||
Molecular Weight |
84489 Da
|
||
Cellular Localization |
Antigen Cellular Localization:
Cell membrane; Peripheral membrane protein
|
||
Host |
Rabbit
|
||
Species Reactivity |
Human, Mouse
|
||
Target |
A synthetic peptide corresponding to residues near the C-terminus of human MARK3 was used as an immunogen.
|
||
Clone |
EPR633Y
|
||
Symbol |
CTAK1, EMK2
|
||
GeneID |
|||
UniProt ID |
|||
Function |
Involved in the specific phosphorylation of microtubule- associated proteins for tau, MAP2 and MAP4. Phosphorylates CDC25C on 'Ser-216'. Regulates localization and activity of some histone deacetylases by mediating phosphorylation of HDAC7, promoting subsequent interaction between HDAC7 and 14-3-3 and export from the nucleus.
|
||
Summary |
MARK3 is a dual-specificity protein kinase that controls entry into mitosis by dephosphorylating Cdc2 on both threonine 14 and tyrosine 15. MARK3 is phosphorylated on serine 216 throughout interphase but not during mitosis. Serine 216 phosphorylation mediates the binding of 14-3-3 protein to MARK3, and MARK3/14-3-3 complexes are present throughout interphase but not during mitosis (1). Kinase suppressor of Ras (KSR) is a conserved component of the Ras pathway that interacts directly with MEK and MAPK. It has been shown that KSR1 translocates from the cytoplasm to the cell surface in response to growth factor treatment and that this process is regulated by MARK3 (2). MARK3 seems to be a positive regulator of the beta-catenin pathway and an inhibitor of the JNK pathway. These findings show that MARK3, a regulator of polarity, is also a modulator of Wnt-beta-catenin signaling, indicating a link between two important developmental pathways (3).
|
||
Form |
50 mM Tris-Glycine (pH 7.4), 0.15 M NaCl, 40% Glycerol, 0.01% sodium azide and 0.05% BSA. |
||
Storage & Stability |
Store at +4°C short term. For long-term storage, aliquot and store at -20°C or below. Stable for 12 months at -20°C. Avoid repeated freeze-thaw cycles.
|
||
Applications |
WB, IHC
|
||
Dilution |
WB~~1:1000~10000
IHC~~1:100~250
|
||
Synonyms |
MAP/microtubule affinity-regulating kinase 3, C-TAK1, cTAK1, Cdc25C-associated protein kinase 1, ELKL motif kinase 2, EMK-2, Protein kinase STK10, Ser/Thr protein kinase PAR-1, Par-1a, Serine/threonine-protein kinase p78, MARK3, CTAK1, EMK2
|
||
Images |

A. Western blot analysis on HeLa cell lysate using anti-MARK3 RabMAb (Cat. APR17319G), dilution 1:2000
B. Immunohistochemical staining of paraffin-embedded human urinary bladder using anti-MARK3 RabMAb (Cat. APR17319G). |
||
Specification |
|||
Quantity |
|
||
| Select | Brand | Catalog No. | Product Name | Pack Size | Type | Field of Research | Specification | Quantity | Price(USD) | |
| 1 | Leading Biology | APG02467G | CCK4 / PTK7 Antibody (clone 4F9) | 50 μl | Monoclonal Antibodies |
|
$495.00 | Add Ask | ||
| 2 | Leading Biology | AMM04683G | GALT Antibody (clone 4C11) | 50 μg | Monoclonal Antibodies |
|
$545.00 | Add Ask | ||
| 3 | Leading Biology | AMM01402G | Vimentin (Mesenchymal Cell Marker) Antibody - With BSA and Azide | 50 ug | Monoclonal Antibodies |
|
$395.00 | Add Ask | ||
| 4 | Leading Biology | APR08280G | LTA4H / LTA4 Antibody (clone 9G8) | 50 μl | Monoclonal Antibodies |
|
$495.00 | Add Ask | ||
| 5 | Leading Biology | AMM00172G | CD1a / HTA1 (Mature Langerhans Cells Marker) Antibody - With BSA and Azide | 50 ug | Monoclonal Antibodies |
|
$395.00 | Add Ask | ||
| 6 | Leading Biology | AMM05750G | CEBPA Antibody | 100 μl | Monoclonal Antibodies |
|
$545.00 | Add Ask |
 Leading Biology Inc.
2600 Hilltop DR, Building G, B Suite C138
Richmond, CA, 94806
Tel: 1-661-524(LBI)-0262
Email: info@leadingbiology.com
Leading Biology Inc.
2600 Hilltop DR, Building G, B Suite C138
Richmond, CA, 94806
Tel: 1-661-524(LBI)-0262
Email: info@leadingbiology.com
Complete this form and click send to ask us a question, request a quote or simply say hello.

You have 0 item in your cart

You have 0 item in your inquiry list
